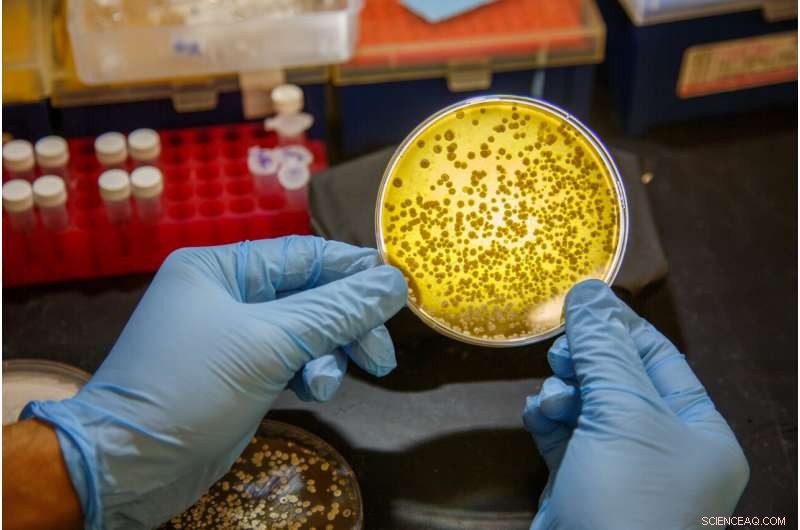
Innovative Enzymatic Approach to Sulfur Incorporation in Complex Molecules

Scientists working in the lab of Ben Shen, PhD, at Scripps Research, Florida have found a new family of sulfur-installing enzymes by mining the genomes of bacteria in their microbial strain collection. Credit: Scott Wiseman for Scripps Research.
A group of highly reactive compounds called persulfides have provoked great curiosity among biochemists, because of their role in nature, and how they interact with proteins to change their structure and function, affecting health, aging and disease processes.
Studying persulfides and their effects has proven challenging, however, due to the chemical's instability. As soon as persulfides are generated, they want to react with nearby molecules before they can be fully investigated.
A new study from the Florida campus of Scripps Research, published in Nature Communications Sept. 28, reveals a previously unrecognized way that nature solves this problem and makes use of persulfides, through the generation of helpful enzymes that play a role in sulfur placement. The discovery provides researchers with a new method for generating potentially important sulfur-based molecules in the lab, and offers an answer to one of nature's fascinating biological mysteries: How does sulfur become integrated into complex molecules in the first place?
Sulfur is the fifth most common element of life, yet nature uses a relatively small number of mechanisms to install it into small molecules, says Ben Shen, professor and chair of the Scripps Research Department of Chemistry in Jupiter, Florida, and senior author of the study.
Shen long wondered how the sulfur atoms could became incorporated into the structure of interesting compounds he studied, including guangnanmycin and leinamycin, given those limited mechanisms.
First discovered in 1989, leinamycin is a natural substance that demonstrates antimicrobial and anticancer properties. With the help of their growing collection of microbial strains, Shen and his team discovered in 2017 dozens of members of what's actually a substantial family of leinamycin variants in nature. Leinamycin's two sulfurs are key to its anticancer activity, Shen found.
The recent acquisition of one of the world's largest microbial strain collections by Scripps Research Florida offered Shen's group a new way to investigate the question, through the targeted search for novel enzymes, nature's catalysts. That process involves growing up larger quantities of the strains of interest, then mining—sequencing and analyzing—their genetic material for telltale signs of enzymes.
"We have now discovered a new mechanism by which nature installs two sulfur atoms into a small molecule at the same time, overcoming the long-lasting challenge in their instability," Shen says. "This particular finding illustrates how powerful our natural product strain collection is, and how it enables us to do things that are innovative."
The natural product collection at Scripps Research in Florida includes more than 125,000 strains of bacteria, which were collected by research groups worldwide during the decades after streptomycin was discovered.
Bacteria from soil must evolve diverse, biologically active natural products to survive in a hostile and competitive world. Those natural products have enormous potential to act as medicines or serve other purposes, if they can be discovered, studied and understood, Shen says.
Constructing these molecules requires the bacteria to act as chemists themselves, devising sometimes innovative processes like new catalytic enzymes, says Song Meng, Ph.D., a lead author of the publication.
"The study of natural products allows us to explore how nature uses simple building blocks to build up the most complex structures humanity has ever seen, which provides opportunities for enzyme discovery and potential impact throughout the entire field of organic chemistry," Meng says.
By learning how Nature builds natural products, the researchers in Shen's lab aim to inspire future efforts in diverse fields such as microbiology, biotechnology, organic chemistry, and medicinal chemistry.
Study coauthors Meng and Andrew Steele, Ph.D., recalled the moment they knew they would achieve their goal.
"We had been working tirelessly to make unstable persulfides. They degrade into smelly hydrogen sulfide, so the first time that we smelled rotten eggs we knew that we had made a breakthrough," Steele says.
Soon after, they discovered the thiocysteine lyases, a family of previously unknown enzymes that nature uses to make persulfides as key intermediates to build the entire leinamycin family of natural products.
The natural products collection has been the key to their success, adds Edward Kalkreuter, Ph.D., a co-author on the paper.
"While traditionally only one biosynthetic pathway could be studied at a time, our strain collection now allows us to discover evolutionarily related families, thereby comparing and evaluating many similar pathways at once," he adds.
The enzymes enabling the persulfide formation are likely to have a broad range of potential applications in the future, they add.
"Persulfides have been found in numerous fundamental and disease-related biochemical systems, but the field of synthetic chemistry has only a few specialized methods at its disposal to generate them," Steele says. "We found nature has provided us with a solution to tackle this problem."
The current discovery enriches the toolbox needed to engineer sulfur-containing compounds, and paves the way for synthetic biologists to develop entirely new classes of molecules to impact chemistry, biology, and medicine, they say.
"I tell my students, if you want to discover something, find how nature does it, that can present a solution," Shen says.